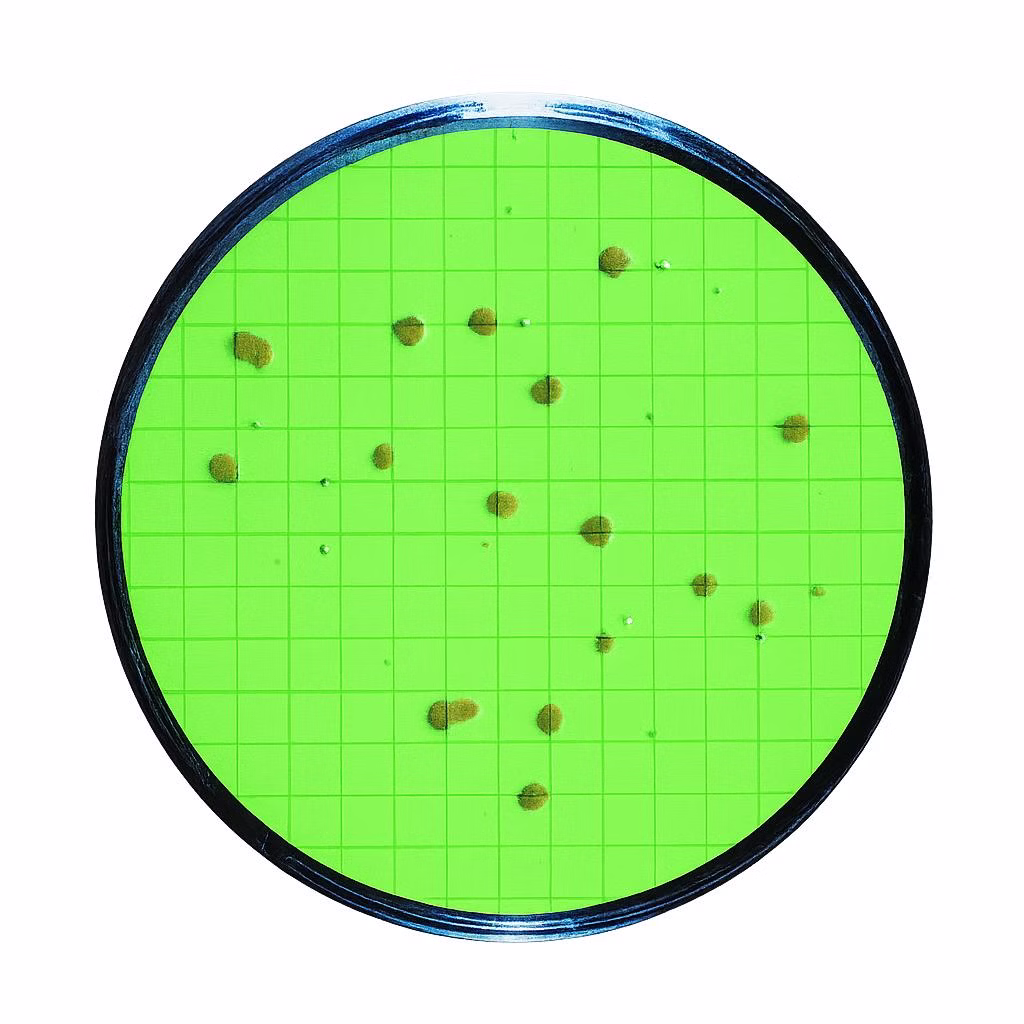

Funktion und Verwendung
Zur Bestimmung der Gesamtkeimzahl. Für Bakterien, Hefen und Schimmelpilze. Bebrütungsbedingungen: 48 Stunden bei 30 °C, in Abhängigkeit vom Untersuchungsmaterial.
Ausstattung und technische Daten
- 10 Stück, mit 10 Membranfiltern
- Durchmesser: 50 mm
- jeweils einzeln und steril verpackt